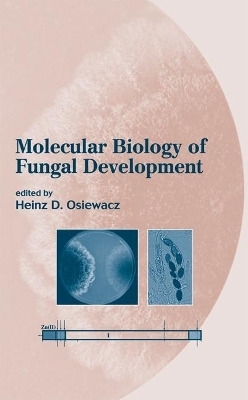
Molecular Biology of Fungal Development -

Molecular Biology of Fungal Development
Crc Press Inc (Verlag)
978-0-8247-0744-6 (ISBN)
- Titel ist leider vergriffen;
keine Neuauflage - Artikel merken
Providing an overview of the fundamental aspects of molecular fungal development, this book covers different elements in the maturational and reproductive cycles of selected fungal taxa. Illustrating various molecular pathways in parasites and hosts, the book explores the development of interventional strategies for combating disease. Highlights include discussions of pseudohyphal yeast growth, hyphal tip growth and genetic control of hyphae fusion, genetic control of aging, spore death, control of the generation of vegetative and sexual reproductive units, symbiotic interactions of fungi with the roots of higher plants, and parasitic interactions of fungi with both plants and animals.
Osiewacz/, Heinz D.
Basic Developmental Processes 1. Pseudohyphal Growth in Yeast 2. Hyphal Tip Growth: Outstanding Questions 3. Conidiation in Aspergillus nidulans 4. Senescence in Podospora anserina 5. Vegetative Incompatibility in Filamentous Ascomycetes 6. Vegetative Development in Coprinus cinereus 7. Blue Light Perception and Signal Transduction in Neurospora crassa 8. Circadian Rhythms in Neurospora crassa 9. Sexual Development in Ascomycetes: Fruit Body Formation of Aspergillus nidulans 10. Sexual Development in Basidiomycetes 11. Spore Killers: Meiotic Drive Elements That Distort Genetic Ratios Interactions of Fungi with Different Hosts 12. Living Together Underground: A Molecular Glimpse of the Ectomycorrhizal Symbiosis 13. Development and Molecular Biology of Arbuscular Mycorrhizal Fungi 14. Pathogenic Development in Ustilago maydis: A Progression of Morphological Transitions That Results in Tumor Formation and Teliospore Production 15. Pathogenic Development in Magnaporthe grisea 16. Pathogenic Development of Claviceps purpurea 17. Hypovirulence 18. Pathogenic Development of Candida albicans 19. Cryptococcus neoformans as a Model Fungal Pathogen 20. Molecular Mechanisms of Pathogenicity of Aspergillus fumigatus
| Erscheint lt. Verlag | 7.5.2002 |
|---|---|
| Verlagsort | Bosa Roca |
| Sprache | englisch |
| Gewicht | 929 g |
| Themenwelt | Naturwissenschaften ► Biologie ► Botanik |
| Naturwissenschaften ► Biologie ► Genetik / Molekularbiologie | |
| Naturwissenschaften ► Biologie ► Mikrobiologie / Immunologie | |
| Naturwissenschaften ► Biologie ► Mykologie | |
| Weitere Fachgebiete ► Land- / Forstwirtschaft / Fischerei | |
| ISBN-10 | 0-8247-0744-3 / 0824707443 |
| ISBN-13 | 978-0-8247-0744-6 / 9780824707446 |
| Zustand | Neuware |
| Informationen gemäß Produktsicherheitsverordnung (GPSR) | |
| Haben Sie eine Frage zum Produkt? |
aus dem Bereich


